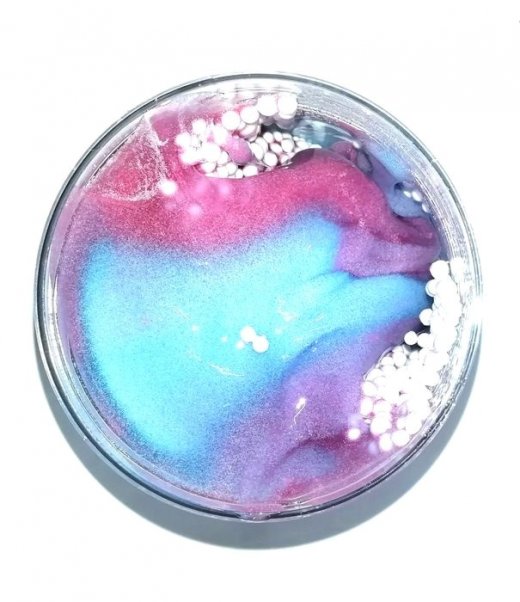

Прошлая цена: 495 руб
Самовывоз из любого магазина
Доставка по городу от 300 руб
Слайм - это удивительная эластичная масса, которая представляет собой жвачку для рук. Вещество обладает невероятными свойствами, благодаря которым с ней можно творить все, на что только хватит детской фантазии. При резком движении его можно порвать, а после склеить обратно. Он обладает тонким и ненавязчивым ароматом, а если оставить слайм "Стекло" на поверхности, то он будет растекаться, как густой кисель. Его текстура напоминает суфле, которое можно тянуть и рвать. Слайм на 80% состоит из воды и на 20% из безопасных полимеров. Он гипоаллергенен, и даже красители в нем пищевые!
Данная жвачка оказывает успокаивающее и расслабляющее воздействие. Способствует развитию мелкой моторики рук, тактильных ощущений, снятию нервного напряжения, усталости и раздражения. Отличный подарок для любого возраста.
Рекомендуемый возраст: от 3 лет.
Материал: пластик, полимер.
Вес: 474 г.
Размер упаковки: 90х95х90 мм
Упаковка: пластиковая баночка.
Купить Слайм стекло Млечный путь 400г в Новосибирске Вы можете в магазине развивающих и настольных игр "Игры Почемучек"
| Артикул: | 00-00000938 |
| Возраст: | от 3 до 5 лет от 5 до 7 лет от 7 до 12 лет от 12 лет |
| Пол: | Мальчик Девочка |